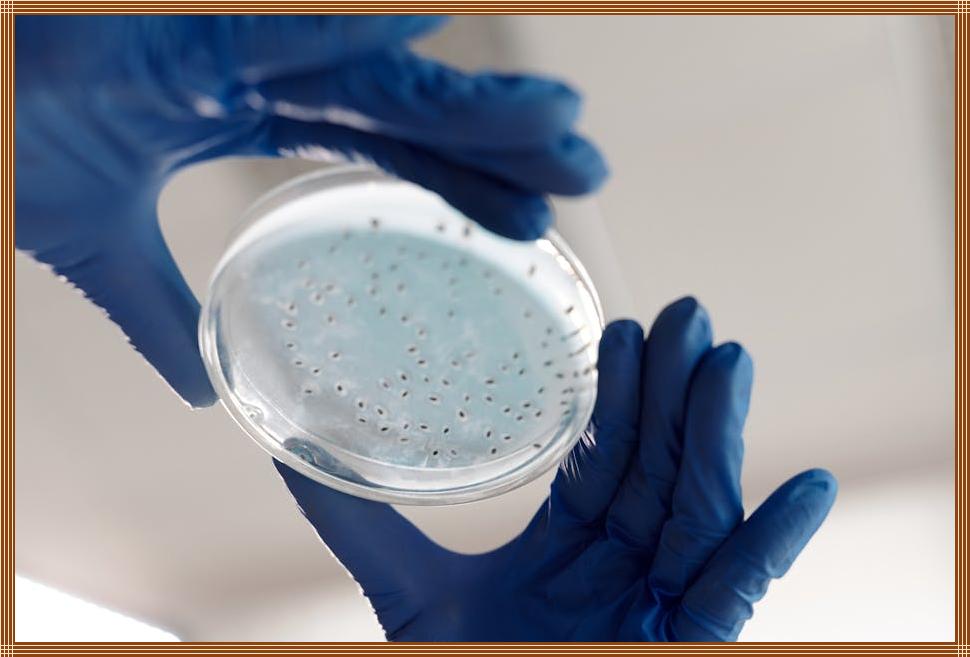

빛은 파동인가, 입자인가? 고대 그리스 철학자들부터 현대 물리학자들까지, 오랫동안 이 질문에 답하기 위해 끊임없이 노력해왔습니다. 그리고 그 해답에 가장 가까이 다가갈 수 있도록 해준 실험이 바로 ‘이중 슬릿 실험’입니다. 이 실험은 빛의 본성에 대한 우리의 생각을 완전히 뒤바꾸어 놓았죠. 빛이 마치 두 개의 문을 동시에 통과하는 듯한 놀라운 현상을 통해, 양자역학의 세계로 우리를 안내합니다. 지금부터 이 신비로운 실험의 세계로 함께 떠나볼까요? 빛의 이중성을 직접 확인해보고, 양자역학의 기본 원리를 이해하는 시간을 가져보세요!
🔍 핵심 요약
✅ 이중 슬릿 실험은 빛의 파동성과 입자성을 동시에 증명하는 실험입니다.
✅ 빛을 슬릿(slit) 두 개를 통과시키면 간섭 무늬가 나타나 파동의 성질을 보입니다.
✅ 전자를 이용한 실험에서도 동일한 간섭 무늬가 나타나 입자도 파동의 성질을 가짐을 보여줍니다.
✅ 이중 슬릿 실험은 양자역학의 기본 원리를 이해하는 데 중요한 역할을 합니다.
✅ 실험 결과는 관찰 행위가 입자의 행동에 영향을 미칠 수 있음을 시사합니다.
빛, 두 얼굴을 가진 존재
빛은 과연 무엇일까요? 고전 물리학에서는 빛을 파동으로, 즉 물결처럼 퍼져나가는 에너지의 형태로 간주했습니다. 하지만 빛이 입자처럼 행동하는 현상도 발견되었죠. 바로 빛의 이중성입니다. 이중 슬릿 실험은 이러한 빛의 두 가지 성질을 명확하게 보여주는 획기적인 실험입니다. 빛이 어떻게 파동과 입자의 성질을 동시에 나타낼 수 있는지, 지금부터 자세히 알아보겠습니다.
파동의 증거: 간섭 무늬
빛의 파동성을 증명하는 가장 중요한 증거는 간섭 무늬입니다. 이중 슬릿 실험에서 빛을 좁은 두 개의 슬릿(slit, 틈새)에 통과시키면, 슬릿을 통과한 빛이 서로 간섭하여 스크린에 밝고 어두운 줄무늬가 나타납니다. 이것이 바로 간섭 무늬입니다. 마치 물결파가 서로 만나 보강 간섭이나 상쇄 간섭을 일으키는 것과 같은 현상이죠. 만약 빛이 입자였다면, 스크린에는 두 개의 슬릿과 일치하는 두 개의 밝은 점만 나타났을 것입니다.
입자의 증거: 광전 효과
광전 효과는 빛이 입자처럼 행동한다는 것을 보여주는 중요한 증거입니다. 금속 표면에 빛을 비추면 전자가 튀어나오는데, 이 현상은 빛이 마치 입자처럼 금속 표면에 충돌하여 에너지를 전달하는 것으로 설명됩니다. 광전 효과 실험에서는 빛의 세기가 아닌, 빛의 진동수가 전자의 방출 여부를 결정하는 중요한 요인으로 작용합니다. 이러한 현상은 빛이 에너지를 덩어리(광자) 형태로 전달한다는 것을 시사합니다.
| 현상 | 설명 |
|---|---|
| 간섭 무늬 | 이중 슬릿 실험에서 빛이 파동처럼 간섭하여 밝고 어두운 줄무늬를 형성함. |
| 광전 효과 | 빛이 금속 표면에 충돌하여 전자를 방출하는 현상. 빛의 입자성을 보여주는 증거. |
이중 슬릿 실험의 원리: 어떻게 작동할까?
이중 슬릿 실험은 매우 간단한 장치로 구성됩니다. 빛을 쏘는 광원, 빛이 통과하는 두 개의 좁은 슬릿, 그리고 빛의 간섭 무늬를 관찰하는 스크린이 필요합니다. 빛이 슬릿을 통과하면서 서로 간섭을 일으켜 스크린에 독특한 무늬를 형성하는데, 이 무늬를 통해 빛의 파동성을 확인할 수 있습니다.
실험 과정: 빛을 쏘아보자
- 광원에서 빛을 쏩니다.
- 빛은 두 개의 좁은 슬릿을 통과합니다.
- 슬릿을 통과한 빛은 스크린에 도달하여 간섭 무늬를 형성합니다.
- 스크린에 나타나는 밝고 어두운 줄무늬를 관찰합니다.
결과 해석: 놀라운 발견
이 실험의 가장 놀라운 점은 빛이 마치 파동처럼 행동한다는 것입니다. 두 개의 슬릿을 동시에 통과하여 간섭 무늬를 만들어내는 현상은, 빛이 파동의 성질을 가지고 있음을 강력하게 시사합니다. 만약 빛이 입자였다면, 스크린에는 두 개의 슬릿 뒤에 해당하는 두 개의 밝은 점만 나타났을 것입니다.
양자역학의 세계로: 입자도 파동이다?
이중 슬릿 실험은 빛뿐만 아니라, 전자와 같은 입자에도 적용됩니다. 전자를 이중 슬릿에 통과시키는 실험에서도 빛과 마찬가지로 간섭 무늬가 나타나는 것을 확인할 수 있습니다. 이는 입자 역시 파동의 성질을 가지고 있다는 것을 의미하며, 양자역학의 기본 원리를 보여주는 중요한 증거입니다.
전자의 이중성: 파동처럼 움직이는 전자
전자를 이중 슬릿에 쏜다고 상상해보세요. 전자는 분명 입자인데, 슬릿을 통과한 후 스크린에 나타나는 모습은 마치 파동처럼 간섭 무늬를 형성합니다. 이 현상은 전자가 두 개의 슬릿을 동시에 통과하는 것처럼 보인다는 것을 의미합니다.
양자 중첩: 여러 상태의 공존
양자역학에서는 입자가 여러 상태를 동시에 가질 수 있다는 개념인 양자 중첩을 설명합니다. 전자는 이중 슬릿을 통과하기 전까지는 두 슬릿을 모두 통과할 수 있는 중첩 상태에 있으며, 관찰하는 순간 하나의 상태로 결정됩니다.
관찰자의 역할: 실험에 영향을 미치는가?
이중 슬릿 실험에서 관찰자의 역할은 매우 중요합니다. 빛이나 전자의 경로를 관찰하려고 시도하면, 간섭 무늬가 사라지고 입자처럼 행동하는 것을 관찰할 수 있습니다. 이는 관찰 행위 자체가 입자의 행동에 영향을 미친다는 것을 의미하며, 양자역학의 독특한 특징 중 하나입니다.
관찰의 역설: 관찰하면 사라지는 간섭
만약 어느 슬릿을 통해 빛이 통과하는지 관찰하려고 하면, 간섭 무늬가 사라지고 마치 입자처럼 행동합니다. 이는 관찰 행위가 입자의 행동을 변화시킨다는 것을 의미합니다.
파동함수의 붕괴: 관찰의 순간
관찰 행위는 입자의 파동함수를 붕괴시켜, 여러 상태의 중첩에서 하나의 상태로 결정되게 합니다. 이 현상은 양자역학에서 관찰이 입자의 행동에 미치는 영향의 핵심을 보여줍니다.
현대 물리학에 미치는 영향: 그리고 미래는?
이중 슬릿 실험은 현대 물리학, 특히 양자역학의 발전에 지대한 영향을 미쳤습니다. 빛과 입자의 이중성을 밝히고, 양자역학의 기본 원리를 이해하는 데 중요한 역할을 했습니다.
양자 컴퓨터: 새로운 기술의 가능성
이중 슬릿 실험을 통해 얻은 양자역학적 원리는 양자 컴퓨터와 같은 새로운 기술 개발에 영감을 주었습니다. 양자 컴퓨터는 기존 컴퓨터보다 훨씬 더 빠른 속도로 복잡한 문제를 해결할 수 있는 잠재력을 가지고 있습니다.